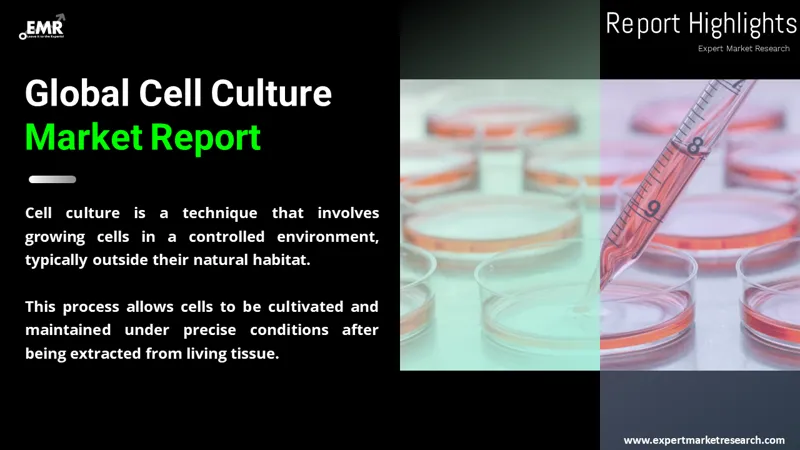

Consumer Insights
Uncover trends and behaviors shaping consumer choices today
Procurement Insights
Optimize your sourcing strategy with key market data
Industry Stats
Stay ahead with the latest trends and market analysis.
The cell culture market was valued at USD 22.87 Billion in 2025, driven by the increasing use of cell-based research in drug discovery and biotechnology applications across the globe. The market is anticipated to grow at a CAGR of 11.30% during the forecast period of 2026-2035, with the values likely to reach USD 66.71 Billion by 2035.
Base Year
Historical Period
Forecast Period
Compound Annual Growth Rate
11.3%
Value in USD Billion
2026-2035
*this image is indicative*
The market for cell cultures is expected to grow as a result of improvements in 3D cell culture technologies and their expanding use in biopharmaceutical manufacturing, drug discovery, and tissue engineering applications. The manufacture of innovative vaccines and biopharmaceuticals has been made possible by recent advancements in gene expression technology, along with the expanding the research and development applications of cell culture techniques. Additionally, the global cell culture market is anticipated to be driven by an increase in cancer research programmes and an expanding range of gene therapy applications. Further, a greater emphasis on cytological studies has resulted from a rise in the prevalence of chronic diseases including cancer and cardiovascular disorders, which has increased demand for culture systems and media products, thereby aiding the cell culture market growth.
As per the cell culture market report, the pharmaceutical industry is rapidly embracing the trend of cell cultures. The cell culture market is expected to generate more income with significant players focusing on biopharmaceutical research and development.
Read more about this report - REQUEST FREE SAMPLE COPY IN PDF
Cell culture is the method through which cells are grown under controlled circumstances, usually outside their natural environment. They can eventually be retained under closely regulated circumstances after the concerning cells have been removed from the living tissue. The cell culture market can be divided based on segments like product, application, and end-use.
The market can be divided based on products as:
The cell culture market can be broadly categorised based on application into:
The market can be divided based on its end uses into:
Looks into the regional cell culture markets like:

Read more about this report - REQUEST FREE SAMPLE COPY IN PDF
The global cell culture market is witnessing significant development owing to the increasing demand for monoclonal antibodies, the rising funding for cell-based studies, the growing preference for single-use techniques, the rising awareness of the advantages of vaccines based on cell culture, and the increased concentration on personalised medicine. As per the cell culture market forecast, the segment of sera, media, and reagents is anticipated to account for a significant share of cell culture consumables markets. Since reagents are crucial to the success of cell models that physiologically relevant, the cell culture reagents market is expected to witness steady growth. During the forecast period, single-use bioreactors are expected to witness substantial development.
The report presents a detailed analysis of the following key players in the global cell culture market, looking into their capacity, market shares, and latest developments like capacity expansions, plant turnarounds, and mergers and acquisitions:
The EMR report gives an in-depth insight into the market by providing a SWOT analysis as well as an analysis of Porter's Five Forces model.
*While we strive to always give you current and accurate information, the numbers depicted on the website are indicative and may differ from the actual numbers in the main report. At Expert Market Research, we aim to bring you the latest insights and trends in the market. Using our analyses and forecasts, stakeholders can understand the market dynamics, navigate challenges, and capitalize on opportunities to make data-driven strategic decisions.*
Get in touch with us for a customized solution tailored to your unique requirements and save upto 35%!
The market was valued at USD 22.87 Billion in 2025.
The market is anticipated to grow at a CAGR of 11.30% during the forecast period of 2026-2035, with the values likely to reach USD 66.71 Billion by 2035.
The market is estimated to witness a healthy growth in the forecast period of 2026-2035 to reach USD 66.71 Billion by 2035.
The major drivers of the cell culture market include the rising demand for monoclonal antibodies, and the increasing funds for cell-based studies.
The growing preference for single-use techniques is a key trend propelling the growth of the market.
The major regions in the market are North America, Latin America, the Middle East and Africa, Europe, and the Asia Pacific.
The various applications of cell cultures in the market are biopharmaceutical production, diagnostics, drug screening and development, stem cell research, and tissue engineering and regenerative medicine, among others.
The primary end uses of cell cultures are biotechnology companies, pharmaceutical companies, academic institutes, and research institutes.
Cell culture refers to the process in which specific cells are grown in a controlled environment for further use.
The major players in the market are Sartorius AG, Thermo Fisher Scientific Inc., Eppendorf AG, Corning Incorporated, Becton, Dickinson and Company, Merck KGaA, Lonza, Bio-Rad Laboratories, Inc., BioTechne Corporation, BioSpherix®, Ltd, Synthecon, Incorporated, and SKE Research Equipment®, among others.
Explore our key highlights of the report and gain a concise overview of key findings, trends, and actionable insights that will empower your strategic decisions.
| REPORT FEATURES | DETAILS |
| Base Year | 2025 |
| Historical Period | 2019-2025 |
| Forecast Period | 2026-2035 |
| Scope of the Report |
Historical and Forecast Trends, Industry Drivers and Constraints, Historical and Forecast Market Analysis by Segment:
|
| Breakup by Product |
|
| Breakup by Application |
|
| Breakup by End Use |
|
| Breakup by Region |
|
| Market Dynamics |
|
| Competitive Landscape |
|
| Companies Covered |
|
| Report Price and Purchase Option | Explore our purchase options that are best suited to your resources and industry needs. |
| Delivery Format | Delivered as an attached PDF and Excel through email, with an option of receiving an editable PPT, according to the purchase option. |
Datasheet
One User
USD 3,299
USD 2,969
tax inclusive*
Single User License
One User
USD 5,499
USD 4,949
tax inclusive*
Five User License
Five User
USD 6,999
USD 5,949
tax inclusive*
Corporate License
Unlimited Users
USD 8,199
USD 6,969
tax inclusive*
*Please note that the prices mentioned below are starting prices for each bundle type. Kindly contact our team for further details.*
Flash Bundle
Small Business Bundle
Growth Bundle
Enterprise Bundle
*Please note that the prices mentioned below are starting prices for each bundle type. Kindly contact our team for further details.*
Flash Bundle
Number of Reports: 3
20%
tax inclusive*
Small Business Bundle
Number of Reports: 5
25%
tax inclusive*
Growth Bundle
Number of Reports: 8
30%
tax inclusive*
Enterprise Bundle
Number of Reports: 10
35%
tax inclusive*
How To Order
Select License Type
Choose the right license for your needs and access rights.
Click on ‘Buy Now’
Add the report to your cart with one click and proceed to register.
Select Mode of Payment
Choose a payment option for a secure checkout. You will be redirected accordingly.
Gain insights to stay ahead and seize opportunities.
Get insights & trends for a competitive edge.
Track prices with detailed trend reports.
Analyse trade data for supply chain insights.
Leverage cost reports for smart savings
Enhance supply chain with partnerships.
Connect For More Information
Our expert team of analysts will offer full support and resolve any queries regarding the report, before and after the purchase.
Our expert team of analysts will offer full support and resolve any queries regarding the report, before and after the purchase.
We employ meticulous research methods, blending advanced analytics and expert insights to deliver accurate, actionable industry intelligence, staying ahead of competitors.
Our skilled analysts offer unparalleled competitive advantage with detailed insights on current and emerging markets, ensuring your strategic edge.
We offer an in-depth yet simplified presentation of industry insights and analysis to meet your specific requirements effectively.
Share